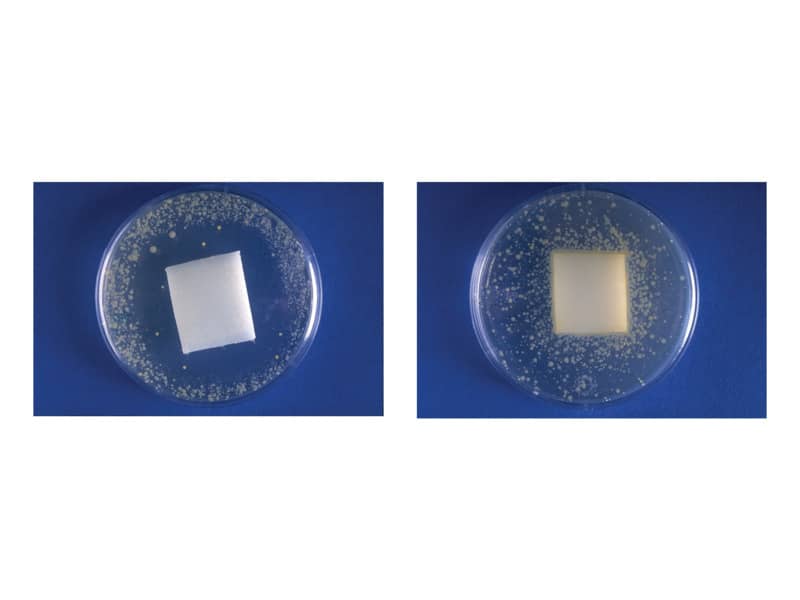

1
/
su
12
Fellowes
Supporto FELLOWES palmare Easy Glide Health V nero 9373003
Prezzo di listino
€46,36
Prezzo di listino
Prezzo di vendita
€46,36
Prezzo unitario
/
per
Imposte incluse.
Spese di spedizione calcolate al check-out.
Impossibile caricare la disponibilità di ritiro
Easy Glide si muove senza sforzo insieme alla mano per incoraggiare un movimento pieno e naturale senza perdere il contatto con il mouseIl canale Health-V™ allevia la pressione sul polso per aiutare a prevenire la sindrome del tunnel carpale. Il materiale soffice e comodo fornisce un supporto auto conformante e promuove una postura neutrale della mano. Idoneo per mouse ottici e laser. La protezione Microban combatte la proliferazione di batteri pericolosi per tutta la durata della vita del prodotto. Certificato BS EN ISO 9241 da FIRA International, un ente indipendente di accreditamento sull'Ergonomia.
Share